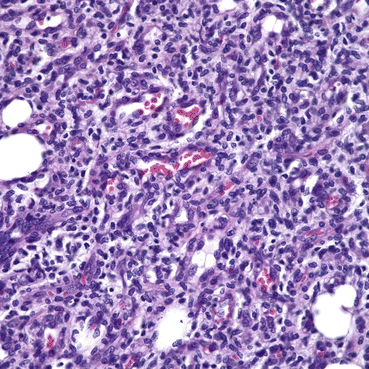
A193575_1_En_8_Fig6_HTML.gif

Fig. 8.1
(a) Adolescent male with PWS; (b) same male with PWS at 42 years of age. Note vascular nodules and soft tissue hypertrophy in (b) (Reprinted with permission from [9])
Histopathological studies of PWS show a normal epidermis overlying an abnormal plexus of dilated blood vessels located in the upper 0.8–1 mm of the dermis [11]. However, vessels throughout the entire skin thickness are abnormally dilated [11]. Electron microscopy exhibits vascular dilatations confined to postcapillary venules and thickening of the walls of the dilated venules [12, 13]. The endothelium of PWS blood vessels contains fenestrations and/or small gaps. Various alterations in the intervascular connective tissue have also been documented [13].
Pathogenesis of PWS
The pathogenesis of PWS remains incompletely understood. However, many lines of evidence have suggested that the nervous system is involved in the pathogenesis of PWS. Lesions on the face appear in the areas innervated by one or more branches of the trigeminal (V1, V2, V3) nerve. In a study of 310 PWS patients, 99 PWS were located on the area innervated by the second (V2) branch of the trigeminal nerve (32%), 128 in the combined first and second (V1, V2) branches (41%), 17 in the combined second and third (V2, V3) branches (5%), and 30 in all three branches (V1, V2, V3) (10%) [14]. The same study also showed that when PWS was involved in all three branches there was a significantly higher likelihood of eye and/or central nervous system complications.
Several studies have shown that there is a deficiency of nerve innervation to PWS vessels. Smoller et al. found, when staining the neural tissue with a S-100 antibody, that only 17% of the vessels in a PWS course with nerves, as compared to 89% in normal skin or hemangioma tissues [15]. Rydh et al. showed after staining the nerve fibers with antibodies against neuron specific enolase, calcitonin gene-related peptide and neurofilament, that pathologically dilated vessels in the middle and deep dermis had defective innervation with only single or no nerve fibers in their vicinity while other structures in the skin have a normal density of nerve fibers [16]. Selim et al. showed when staining the nerve fibers with an antibody against protein gene product 9.5 that nerve density was significantly decreased in all PWS sites as compared to normal skin [17]. Furthermore, when epinephrine was injected into the PWS dermis, the ectatic vessels did not constrict [18], suggesting that defects in proper tonic modulation received from the sympathetic nervous system leads to progressive ectasia of thin-walled vessels. Collectively, the lack of blood vessel innervation may contribute to the development of a PWS as a direct result of decreased tonus of the vessels and/or a loss of neuronal trophic factors.
Treatment of PWS
Historical treatments for PWS included skin grafting, ionizing radiation, dermabrasion, cryosurgery, and electrotherapy. Clinical results were unsatisfactory due to cosmetically unacceptable scarring post-treatment. The current treatment of choice for PWS is pulsed dye laser (PDL) therapy which is based on the theory of selective photothermolysis. This theory describes a method to selectively destroy subsurface-targets without inducing thermal damage in adjacent normal tissue [19]. To achieve this goal, a proper wavelength that is absorbed preferentially by a chromophore in the target, such as hemoglobin, should be chosen. To limit the amount of heat diffusing into the surrounding tissue during light exposure, the duration of laser irradiation should be on the order of the target’s thermal relaxation time which is defined as the time required for the target to cool to one half of its peak temperature immediately after laser irradiation.
The first generation of PDL had a wavelength of 577 nm and pulse duration of 300 μs which was shown to cause selective vascular destruction in PWS skin without evidence of scarring [20]. A change in wavelength from 577 to 585 nm resulted in deeper penetration of the laser light and deeper blood vessel injury which is required for adult PWS treatment [21]. The incorporation of the dynamic cooling device into the PDL allows selective cooling of the epidermis, which is prone to injury due to light absorption by melanin, while leaving the temperature of the PWS blood vessels unchanged [22]. Dynamic skin cooling has permitted the use of higher light dosages to expedite PWS lesion clearance without producing complications such as dyspigmentation or scarring [23].
Despite the advancement in PDL and skin cooling techniques, complete PWS clearance is rarely achieved in the majority of cases even after multiple PDL treatments. Van der Horst et al. treated 89 patients with PWS aged from infancy to 31 years using the PDL [24]. The average reduction in PWS color was only 40%, and no patients had 100% clearance of their PWS after 5 treatments. In a study by Yohn et al. on 74 adult patients treated using the PDL, only 36.5% achieved 50% clearing, and no patients had 100% clearance of their PWS after 3–16 treatments [25]. A recent review by Lanigan and Taibjee concluded that “it remains difficult to eradicate PWS fully with our current armory of lasers and noncoherent light sources” [26].
Many factors contribute to incomplete PWS blanching. Epidermal melanin limits the light dosage that can be safely applied and reduces light delivery to targeted PWS vessels. When the PWS blood vessels are too small or too large, heat cannot be confined to or fill the entire lumen [27–29]. Regrowth and reperfusion of photocoagulated blood vessels can cause PWS redarkening or treatment failure [30, 31]. We believe that the regrowth and reperfusion of blood vessels post-PDL treatment is a critical barrier to achieving an adequate PWS therapeutic outcome. As shown in Fig. 8.2, PDL resulted in intense purpura with histological documentation of vascular wall necrosis. However, the laser-induced wound healing response to PDL treatment often results in regrowth and reperfusion of PWS blood vessels within 1 month after laser exposure. As stated by Phung et al. [31], “the laser does what it is supposed to do, namely, cause blood vessel wall necrosis. Regrettably, the body also does what it is supposed to do, namely, repair the laser-induced damage.”


Fig. 8.2
(a), PWS before PDL treatment; (b), 2 days after treatment; (c), 1 year after PDL. Despite intense purpuric response induced by PDL treatment, the PWS blood vessels have reformed (Reprinted with permission from [31])
Angiogenesis and Vasculogenesis After PDL-Treatment
PDL treatment of PWS causes intense, acute damage to blood vessels [31, 32]. The skin’s normal wound healing response detects hypoxia and initiates appropriate defense mechanisms, such as angiogenesis. The PDL-induced local hypoxia leads to upregulation of hypoxia-inducible factor-1alpha (HIF-1α), a master modulator for hypoxic response [33, 34] and vascular endothelial growth factor (VEGF) [33, 34], which subsequently activates many angiogenic signaling pathways and ultimately results in the regrowth and reperfusion of PWS blood vessels.
HIF-1α is known to control the expression of hundreds of genes involved in angiogenesis, inflammation, bioenergetics, proliferation, motility and apoptosis [35, 36]. As the key angiogenic molecule acting in response to oxygen concentration, HIF-1α is regulated at multiple levels in response to hypoxia. First, HIF-1α mRNA expression increases under hypoxia or ischemia. Many studies have shown that HIF-1α mRNA increases in response to hypoxia in rodents [37–40] and humans [41, 42]. Furthermore, the stabilization of HIF-1α mRNA may also contribute to the sustained increase of its mRNA [37]. Second, HIF-1α protein is synthesized and accumulated as a result of hypoxia stimulation. Hypoxia activates the mammalian target of rapamycin (mTOR) signaling pathway that plays a very important role in stimulation of the synthesis of HIF-1α protein and its transcriptional activities [36, 43]. HIF-1α has been shown as the downstream target of mTOR with an mTOR signaling motif located in its N terminus, which can interact with the regulatory associated protein of mTOR (Raptor) [43]. This pathway affects the translational levels of HIF-1α and serves as an amplifier for maximal expression of HIF-1α rather than the essential trigger for its activation [43].
The mRNA and protein levels of HIF-1α are significantly upregulated in animal skin irradiated by PDL as compared to normal skin [44]. In a hamster model, when the blood vessels are destroyed by laser [32, 44], the hypoxia induced by laser exposure is very severe and persistent for days until the vessels are fully reformed and reperfused. Thus, the increase of HIF-1α protein levels after laser treatment may be the result of both an increase in its mRNA level and translation rate. Furthermore, other angiogenic related biological processes, such as wound healing, defense and inflammatory responses, may also contribute to the increase in HIF-1α protein and mRNA levels in response to laser irradiation.
VEGF is the growth factor that plays a predominant role in angiogenesis pathways. VEGF can activate the vascular endothelial growth factor receptor 2 (VEGFR-2) which can then render the full range of VEGF responses such as endothelial cell proliferation, migration and formation of vascular tubulin [45, 46]. VEGF and HIF-1α can be upregulated reciprocally through angiogenesis pathways. VEGF is one of the downstream targets of HIF-1α. Hypoxia-activated-HIF-1α can translocate into the nucleus and directly bind to the hypoxia response element of the VEGF promoter and activate its transcription, thus leading to an increase in VEGF mRNA levels [43, 47–49]. Alternatively, VEGF can increase HIF-1α mRNA translation into protein via phosphoinositide 3-kinase (PI3K) /AKT signaling [48, 50].
Both skin mRNA and protein levels of VEGF have been shown to increase significantly in a hamster animal model post-PDL exposure as compared to non-irradiated control skin [44], indicating an active role of VEGF in the angiogenesis process induced by laser irradiation. As the receptor of VEGF, which initiates the angiogenesis pathway, the protein level of VEGFR-2 is upregulated in laser-treated hamster skin as compared to non-irradiated control skin [51]. The 70 kDa ribosomal S6 kinase (S6) and AKT, the two main downstream molecules of VEGF, demonstrate an increase in their phosphorylation levels after PDL exposure [44], which suggests that the PIK3/AKT/mTOR pathway is activated through VEGF/VEGFR-2 signaling.
A schematic of the angiogenesis pathways in skin post-PDL exposure is outlined in Fig. 8.3. Briefly, PDL-induced hypoxia stabilizes and translocates HIF-1α into the nucleus as the initial step to trigger angiogenesis pathways. HIF-1α can bind to the hypoxia response element on promoters of many angiogenic genes, thus facilitating their transcription. These angiogenic growth factors, such as VEGF, fibroblast growth factor 2 (FGF2) and platelet-derived growth factor beta polypeptide (PDGFB), are regulated by HIF-1α at the transcriptional level and mTOR/S6 kinase signaling at the translational level. Ultimately, these factors are secreted into the extracelluar space between cells. These secreted growth factors bind to and activate their receptors, such as VEGFR2, FMS-like tyrosine kinase 1 (FLT1), fibroblast growth factor receptor 2 (FGFR2) and PDGF receptor, alpha polypeptide (PDGFRA), on adjacent cells. Activation of these receptors leads to the activation of multiple signaling pathways in adjacent cells, such as protein kinase C (PKC), endothelial nitric oxide synthase 3 (NOS3), PI3K/AKT, protein tyrosine kinase 2 (PTK2), SHC transforming protein 1 (SHC1)/mitogen-activated protein kinase (MAPK). These signaling pathways play important roles in cell proliferation, survival, migration, cytoskeletal rearrangement and blood vessel stabilization, which ultimately contribute to angiogenesis (Fig. 8.3).


Fig. 8.3
A schematic of angiogenesis pathways activated by PDL exposure
In addition to angiogenesis, vasculogenesis may also be involved in regrowth and reperfusion of photocoagulated blood vessels. Recent evidence has shown that endothelial stem cells have been recruited into skin sites where blood vessel were photocoagulated [52], suggesting the possible role of vasculogenesis in the regrowth and reperfusion of blood vessels. Circulating endothelial stem cells are characterized by the expression of the cluster of differentiation 133 (CD133) [53] while mesenchymal stem cells are characterized by the expression of the cluster of differentiation 166 (CD166) [54]. After human skin is exposed to PDL, the stem cell marker nestin is strongly expressed in the proliferating endothelial cells but not CD133 or CD166 [52]. Nestin-expressing stem cells are primarily located in the hair follicular bulge region and contribute to the growth of new vessels in injured skin [55]. These results together suggest dermal follicular-derived, rather than bone marrow-derived, endothelial stem cells are locally recruited for the regrowth and reperfusion of PDL-injured blood vessels. However, the stem cell marker nestin is also upregulated in proliferating endothelial cells in human tumors [56, 57] and in activated endothelial cells in inflammation [58]; thus, additional work is needed to investigate the possible role of vasculogenesis during regrowth and reperfusion of PDL-injured skin blood vessels.
Anti-angiogenic Therapy for PWS Treatment
Presently, PDL treatment for PWS is inadequate to achieve complete lesion blanching due to regrowth and reperfusion of photocoagulated PWS blood vessels. In the pathophysiological process of PWS blood vessels regrowth and reperfusion, activation of angiogenesis pathways plays a major role. Thus, anti-angiogenic therapeutic strategies combined with PDL may potentially enhance PWS therapeutic outcome. Many anti-angiogenic drugs have been developed to target different signaling pathways in angiogenesis and have been approved by the US Food and Drug Administration for treating certain cancers [59]. However, only angiogenesis inhibitors without serious side effects should be used to treat PWS patients. One such compound is rapamycin (RPM) which has a long history of human use as an immunosuppressant with a relatively low side effect profile [60].
RPM can inhibit mTOR activity by forming a complex with FK-binding protein 12 and then binding to mTOR directly [61–63]. RPM has been used: (1) for immunosuppression in renal transplantation subjects [64]; (2) as anti-cancer therapy due to inhibition of tumor cell survival and angiogenesis [61, 65, 66]; and (3) for the treatment of hypervascular anomalies including angiomyolipomas [67–70] and many skin diseases, including Kaposi’s sarcoma [42, 71, 72], psoriasis [73] and angiofibromas [74].
A preclinical animal study has been conducted to show the feasibility of anti-angiogenic therapy for PWS treatment. The animal model used in this study is the dorsal window chamber installed on Golden Syrian hamsters. The model consists of a lengthwise fold of dorsal skin held with two titanium frames. One layer of skin within the frame’s observation window was cut to expose the subdermal blood vessels in the underlying intact skin. This model permits in vivo visualization and irradiation of the subdermal blood vessels.
Laser irradiation was performed on the subdermal side of the skin through the window glass. Blood vessels were irradiated with a frequency-doubled Nd:YAG laser (532 nm wavelength). The pulse duration was 1 ms and the radiant exposure varied from 3 to 5 J/cm2. The laser spot size was 2 mm (circles in Fig. 8.4). The number of pulses varied from 1 to 5 and the pulse repetition rate was 20 Hz.


Fig. 8.4
(a), (Laser alone) Photos of the subdermal side of the window chamber before and after Laser alone treatment and 14 days later. At Day 14, blood vessel regrowth was observed. (b), (Laser+RPM) Laser plus 1% topical RPM treatment show little blood vessel regrowth and reperfusion 14 days after laser irradiation (Reprinted with permission from [31, 32])
Topical RPM was applied onto the epidermal side of the skin in the window chamber immediately after laser irradiation and daily thereafter for 14 days. The RPM formula contained 1% RPM powder dissolved in 5% benzyl alcohol and thoroughly mixed with a skin penetration enhancer and an ointment base (Conrex Pharmaceuticals, Newtown Square, PA).
To document the structural and functional changes of blood vessels induced by laser irradiation or drug intervention, digital color photos and laser speckle images (LSI) of the windows were acquired prior to, shortly after laser irradiation, and daily thereafter for 2 weeks. LSI was used to determine blood flow dynamics in the window [75].
When animal skin was exposed to laser, acute vessel injury with a reduction or stoppage in blood flow was observed immediately after exposure. However, regrowth and reperfusion of the blood vessels were completed by day 14 when laser was used alone, a process that is normally observed within 10 days post-laser irradiation (Fig. 8.4 – Laser Alone). In contrast, there were little regrowth and reperfusion of blood vessels after light-induced blood vessel coagulation in conjunction with daily topical application of RPM (Fig. 8.4 – Laser+RPM). Even after RPM was discontinued for 21 days, only 20% regrowth and reperfusion was observed in the skin microvasculature during this period [31, 32].
Our recent study showed that the VEGF/AKT/mTOR pathway activated by PDL irradiation can be suppressed by RPM [76]. In an animal model, topical application of RPM suppressed the PDL-induced increase in mRNA and protein levels of VEGF on day 3 post-PDL exposure. The upregulation of phosphorylation levels of S6 (Ser411) and AKT (Ser473) induced by PDL exposure was also suppressed with RPM, which is consistent with studies with other animal and disease models [77, 78]. One possible mechanism to inhibit VEGF by topical RPM is that the suppression of mTOR with RPM downregulates HIF-1α levels and thus decreases its transcriptional activity to the VEGF promoter [61, 79–82].
Similar to VEGF, the PDL-induced increase in mRNA and protein levels of HIF-1α can also be suppressed by topical application of RPM [76]. RPM has been demonstrated to downregulate hypoxia-induced HIF-1α protein and mRNA levels in many other tissues and models [43, 79–81, 83]. The proposed mechanism is that RPM can directly suppress the translation process of HIF-1α through inhibition of mTOR signaling and modulate HIF-1α activity via a Von Hippel-Lindau-independent mechanism, but RPM does not affect the stability of HIF-1α protein [43].
A pilot clinical study has been conducted to determine the safety and efficacy of combined oral RPM and PDL therapy on PWS test sites in comparison to standard PDL therapy [84]. The hypothesis is that PDL can cause PWS blood vessel injury and RPM can prevent blood vessels regrowth and reperfusion after laser therapy which will improve PWS lesion blanching response.
An adult male PWS patient with a lesion involving his left chest was recruited. Three test sites with a diameter of 2.5 cm were selected (Fig. 8.5a) and treated by PDL alone as controls. One month after PDL alone exposure, the subject was given 2 mg RPM per day orally. On the seventh day after daily RPM intake, three additional test sites were then treated by PDL using the same parameters as the PDL alone test sites. The subject continued taking oral RPM for 4 weeks after the second laser exposure.


Fig. 8.5
PDL alone vs. oral RPM + PDL. Blanching responses by test sites and treatment: (a) before treatment; (b) 6 weeks after treatment; (c) 8 months after treatment; and (d) 13 months after treatment (Reprinted with permission from [84])
Photographs of the test sites at baseline, 6 weeks, 8 and 13 months are shown in Fig. 8.5a, b, c, d. On the PDL alone test site, some blanching was observed at 6 weeks after treatment (Fig. 8.5b). However, the test sites progressively darkened to almost unidentifiable at 8 and 13 months (Fig. 8.5c, d). In contrast, the test sites treated with the combined oral RPM and PDL therapy had better blanching responses as compared to PDL alone at 6 weeks after treatment (Fig. 8.5b). Even more impressively, the blanching of the test sites treated with the combined therapy has been maintained long-term for more than 13 months after treatment (Fig. 8.5c, d).
No abnormal wound healing, skin texture change and dyspigmentation was observed on any test site. Blood and urine test results at 2 and 4 weeks after the second laser treatment were within normal limits (trace protein noted on urinalysis.)
In summary, PWS is a congenital vascular malformation of skin with development of progressive blood vessel dilation within the lesion. A defect in nervous innervation to PWS blood vessels has been proposed to contribute to the pathogenesis of PWS. PDL treatment of PWS is inadequate to achieve complete lesion blanching due to regrowth and reperfusion of PWS blood vessels after PDL treatment. Angiogenesis pathways play critical roles in the pathophysiological process of regrowth and reperfusion of PWS blood vessels after PDL exposure. Multiple signaling pathways, including VEGF, FGF2 and PDGFB, are activated in response to PDL exposure. Thus, anti-angiogenic therapy combined with PDL should be considered as the future focus on new therapeutic strategies for PWS. One anti-angiogenic drug, RPM, can efficiently suppress the VEGF/PI3K/AKT/mTOR pathway and inhibit reperfusion of blood vessels post-PDL exposure in an animal model and PWS patients.
Infantile Hemangioma (IH)
Infantile hemangiomas (IH) are the most common tumors of infancy and occur in 4–5% of infants by 1 year of age. The majority of lesions are noted within the first few weeks of life [85]. For most children, the lesions are small and take on an uncomplicated course, but some hemangiomas grow dramatically so as to destroy tissue, impair function, or threaten life. A unique and defining feature of infantile hemangiomas is their remarkably predictable biologic behavior: a rapid proliferating phase followed by a slow spontaneous involution characterized by apoptosis and disappearance of capillaries with replacement by loose fibrofatty tissue. In the past decade, there have been immense advances in the pathogenesis of hemangiomas, providing us with insight on treatment and stimulating vascular regression.
Historical Perspective of Hemangiomas
The first theory on vascular tumors was developed in the 1950s, when light microscopy of IH revealed abnormal endothelia with cells forming poorly organized buds and irregular vascular spaces. It was postulated that IH developed from islands of angioblastic mesenchyma that were isolated from systemic vasculature during fetal development [86]. In the past few decades, new histopathologic techniques at the molecular and cellular level have significantly improved our understanding of these tumors.
The following review will discuss these findings and theories on the pathogenesis of IH. Several hypotheses have been proposed to explain their pathogenesis, but no single theory accounts for all of their features. Our current understanding of IH suggests that the pathogenesis is multifactorial, and that multiple genes, in addition to local effects, play a role in the development, growth and involution of IH.
Pathophysiology and Life Cycle of Infantile Hemangiomas
Infantile hemangiomas represent localized or regional areas of abnormal vascular development and proliferation. Histopathologic evaluation of tissue reveals characteristic findings in each phase of the life cycle.
The proliferating phase is characterized by the rapid proliferation of primitive cells and occurs during the first few weeks after birth to the end of infancy. Microscopically, IH demonstrate increased endothelial cellularity, formation of syncytial masses without a defined vascular architecture, proliferating endothelial cells and pericytes that focally form lumina containing red cells (Fig. 8.6) [87]. The endothelial and interstitial cells strongly express a marker of proliferation, MIB1. The number of cells in mitosis greatly exceeds the apoptotic cells and mitotic activity is easily observed in the proliferative phase with apoptosis less frequently detected. CD31+ endothelial cells are clonal and express a particular phenotype [88]: indoleamine 2,3 dioxygenase (IDO), LYVE-1, merosin, CCR6, glucose transporter (GLUT-1), antigen Lewis Y (Ley), and antigen FcRII (CD32). It has also been observed that hematopoietic cells of the myeloid lineage constitute a significant portion of the cells found in hemangiomas, particularly in the proliferative phase. Myeloid cells appear in large numbers during the proliferative phase and participate in angiogenesis through secretion of pro-angiogenic factors [89].

Fig. 8.6
Note the prominent spindle-shaped pericytes in aggregates. The endothelial spaces are scattered amidst these aggregates, and exhibit plump luminal cells. Note the numerous mitoses represented by dark oval, round, and rectangular-shaped structures. There are scattered mast cells and lymphocytes throughout the cellular population
Spontaneous involution typically commences around 1 year of age and into early childhood. During the involution phase, the endothelial cells express caspases, which are known markers of apoptosis [90]. Light microscopy shows apoptotic bodies and increased number of mast cells are present and the endothelium begins to flatten, accompanied by enlargement of the lumen. Mitotic activity ceases and apoptotic cells are easily observed. In addition, a diffuse lymphocytic infiltrate with CD8+ T cytotoxic activity markers is also noted with positive granzyme B expression. This stage corresponds to an increase in the expression of markers of maturation and activation of endothelial cells such as HLA-DR and ICAM-1 (CD54) [91]. As involution proceeds, fibroadipose tissue increases and fills the vessels both within and between lobules (Fig. 8.7) [87, 91]. The origin of the adipocytes has been suggested to be derived from differentiated descendants of the primitive cells present in the proliferating phase and it has been shown that hemangioma stem cells are capable of differentiation into not only endothelial cells, but also adipocytes [92].


Fig. 8.7
As involution proceeds, the areas of endothelial cell proliferation are replaced by islands of stroma and adipocytes. The latest stages of involution exhibit fibro-adipose zones with only a few large vessels as any evidence of a prior vascular lesion at the site
Angiogenesis and Vasculogenesis
Infantile hemangiomas are the result of the rapid development of blood vessels. The growth and involution of IH are unique in their lifecycle of proliferation and involution, and differ from other vascular anomalies, which do not regress over time. Blood vessels develop in vivo from two distinct processes: angiogenesis and vasculogenesis. Postnatal vasculogenesis is relatively uncommon and only occurs in specific circumstances, such as wound healing, placental formation, tumor growth and diseases of the eye [93]. Studies have shown that both angiogenesis and vasculogenesis participate in the formation of blood vessels, however more recent studies suggest that vasculogenesis may have a more important role in the development of IH.
Supporting the theory of angiogenesis is the detection of angiogenic factors such as bFGF and VEGF within the tumor, and up-regulation of angiogenesis-related integrin receptors in proliferating but not involuting IH [89, 94]. VEGF has been implicated in angiogenesis because it specifically induces proliferation of endothelial cells and results in increased vascular permeability. It has been observed that the expression of VEGFR1 in hemangioma endothelial cells and protein levels are abnormally low compared with different control endothelial cells. These low levels of VEGFR1 expression are associated with VEGF-induced activation of VEGFR2 and activation of downstream signaling pathways, which lead to stimulation of angiogenesis. Nuclear factor activated T-cells (NFAT) targets the VEGFR1 gene, resulting in its transcription in endothelial cells; suppression of NFAT increasing VEGF levels [95].
Notch family members have also recently been found to play a role in vascular development during tumor angiogenesis. The pattern of Notch gene expression has been shown to parallel the progression from immature cells to endothelial-lined vascular channels that characterizes the growth and involution of IH [96]. Notch3 was found to be expressed in hemangioma-derived stem cells but not in hemangioma-derived endothelial cells. This finding indicates that Notch3 was associated with proliferation, while increased expression of endothelial-associated Notch proteins Notch1, Notch4 and Jagged-1 was associated with maturation and involution.
More recently, studies have demonstrated that IH may arise from the process of vasculogenesis [97]. This theory suggests that IH may be derived from undifferentiated stem cells or progenitor cells from the placenta or bone marrow [95]. Hemangioma-derived endothelial cells (HemECs) were found to express many of the features of human endothelial cells and common endothelial markers. These cells exhibit clonality and increased rates of proliferation, adhesion and migration in response to endostatin, which normally inhibits migration and growth of mature endothelial cells [98]. These findings suggest that hemangiomas may result from a defect in endothelial differentiation or maturation. Hemangioma-derived endothelial progenitor cells (HemEPCs), a precursor of HemECs, have also been isolated from hemangiomas in the proliferating phase and found to co-express the human stem cell marker CD133 and endothelial cell markers and enhanced migration in response to endostatin. Endothelial progenitor cells (EPC) express HIF1α which in turn promotes local production of VEGF [99]. However, when implanted into immunodeficient mice, EPC was found to be incapable of new blood vessel formation [100]. This led to a search and identification of hemangioma-derived stem cell (HemSC), a multipotent progenitor-like cell that expresses CD90, a mesenchymal cell marker. These cells exhibit clonality and increased rates of proliferation and when implanted into immunodeficient mice, are capable of forming GLUT-1 positive hemangioma-like blood vessels, that subsequently decline and are replaced by adipocytes [92].
Theories of Hemangioma-Genesis and Involution
Placenta Theory
In recent years, there has been increasing evidence suggesting that the placenta is closely related to IH. It has been observed that the natural progression of IH parallels that of the placenta with proliferation in early gestation and stabilization thereafter. GLUT-1 was the first placental marker identified in IH and has become a hallmark histological tool in distinguishing these tumors from other vascular anomalies, in that it is a specific feature of IH during all phases of progression, and was not found in other vascular malformations [101]. In addition to GLUT-1, there is a distinct constellation of tissue-specific markers uniquely co-expressed by IH and placental microvessels, namely FcγRII, LeY and merosin. Other markers including insulin growth factor 2 (IGF2), type II 17-hydroxysteroid dehydrogenase (17HSDb2), tissue factor pathway inhibitor 2 (TFPI-2), type III iodothyronine deiodinase [102] and IDO have been discovered in recent years implying a unique relationship between the placenta and IH [103].
Further support of the placental origin is provided by results of a study using large-scale genomic analysis [104]. Cluster analysis showed that placenta and IH are as similar as normal lung and lung tumors, raising the interesting possibility of viewing the placenta as “tumor” and the hemangioma as “metastasis” [105]. When comparisons were restricted to genes with known expression in endothelial cells, the similarities were even greater; IH was more similar to placental samples than placental samples were to each other. A study by Barnes showed that gene expression of 21 endothelial-associated genes found high correlation coefficient for all IH-placental pairs [104].
Epidemiologic studies also support the placental IH relationship. It has been observed that IH are more prevalent in infants whose mothers underwent chorionic villus sampling. Placental complications such as placenta previa and preeclampsia, infants with premature birth, and lower birth weight are all associated with a higher incidence of the tumor [106, 107]. Trauma from placental complications and chorionic villus sampling may increase the number of placental cells released into the circulation and increase the likelihood of embolization of trophoblasts to fetal vascular sites. One study showed that infants of mothers who underwent chorionic villus sampling had a 10-fold greater incidence of hemangiomas compared with those who did not undergo this procedure [108, 109]. A more recent study, however, did not corroborate this association [107], with another study showing that all hemangioma endothelial cells matched the genotype of the child and not the maternal genotype [110].
Hypoxia Theory
Infantile hemangiomas often exhibit an initial blanched appearance, thought of as a “precursor” area of pallor that precedes the proliferative lesion [111]. The tissue associated with the pallor undergoes a hypoxic insult sensed by cells, which respond by modifying gene expression [112]. These modifications can enhance the ability of the cell to survive low oxygen conditions as well as induce expression of factors that promote the growth of new blood vessels. These transcriptional effects are mediated by HIF1-α, which are stabilized by hypoxia and increased estrogen levels, and upregulated in both the placenta and IH tissue [113, 114]. Of significance, GLUT-1 and insulin-like growth factor 2 (IGF-2) are present in IH at high levels, and are both under the control of HIF-1α and induced by hypoxia [115, 116]. A recent study observed increased GLUT-1 transcription, protein and activity levels in IH endothelial cells that were subjected to hypoxia [117]. As IGF-2 expression is induced under low oxygen conditions, this may explain the high levels of this factor observed during the phase of rapid IH proliferation [118].
Stay updated, free articles. Join our Telegram channel
Full access? Get Clinical Tree





